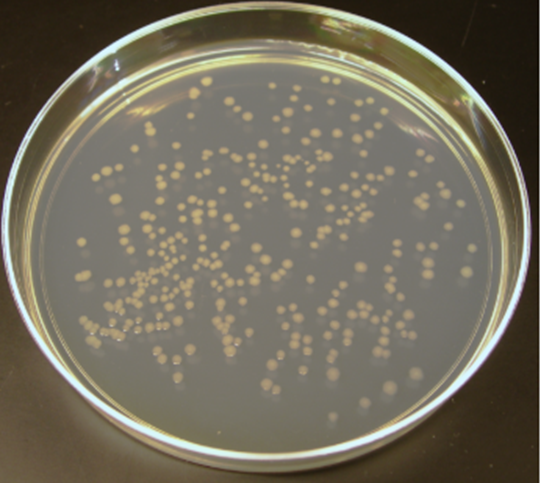
A petri dish with bacteria

|
Head Teacher's Message

Dear Parents and Carers
As we reach the end of the autumn term and look ahead to the Christmas break, I would like to thank you sincerely for your continued support of the school and, most importantly, of your children. This has been an exceptionally full and purposeful term, and I hope you enjoy reading the bulletin which captures just a small snapshot of the learning, experiences and successes that take place here each day. Across the school, students have approached their learning with focus and maturity. Whether in lessons, rehearsals, fixtures, trips or leadership roles, they continue to demonstrate the values that underpin our community: Commitment, Opportunity, Respect and Excellence. It has been a pleasure to see these qualities reflected so consistently in the way students conduct themselves and support one another.
There have been many highlights this term. Students have shown real generosity through charitable initiatives, embraced enrichment opportunities across sport, the arts and STEM, and continued to make strong academic progress. Events such as performances, competitions, assessments and consultation evenings have all reinforced the positive momentum we see across year groups. Congratulations to Binswood College, who finish the term leading the rewards table; the new term will bring further opportunities for all students to be recognised for their effort and contribution.
I would also like to extend my thanks to the many parents and students who have taken the time to write to the school to express their appreciation for staff. These messages are genuinely valued and mean a great deal to colleagues, many of whom have also enjoyed the occasional box of chocolates along the way.
As the term draws to a close, we also send a fond farewell to Mr Sycamore, who is moving into semi-retirement. His contribution to Computing and to wider school life has been immensely valued. Mr Sycamore has worked tirelessly to develop a rich and ambitious curriculum, delivering high-quality outcomes and inspiring growing numbers of young people to study Computing both here and beyond our school. We thank him warmly for his dedication and wish him every happiness in the next chapter. We will, in turn, warmly welcome Mrs Badham at the start of next term. Mrs Badham is a highly skilled and experienced practitioner, and we very much look forward to her joining our community as our new Head of Computing. We also say goodbye to Mrs Moldrick (formerly Ellis-Gormley), who will not be returning from maternity leave. Mrs Moldrick has been an excellent colleague who has worked tirelessly for our students over the past eight years in Geography, and we wish her and her family all the very best for the future.
I would like to acknowledge the exceptional commitment of all our staff, whose professionalism, care and high expectations ensure that students are both supported and challenged to be their very best.
As we pause for the festive period, I wish you and your families a peaceful and enjoyable Christmas. We look forward to welcoming students back refreshed and ready for the opportunities of the spring term on Tuesday 6 January.
Thank you once again for your partnership and support.
With very best wishes
Mike Lowdell
Head Teacher
|
|
|

|
09 Dec 2025
Thank you to everyone who supported our Christmas Jumper Day on Friday 12 December, helping to raise money for Save the Children.
It was lovely to see and see so many students and staff embracing the festive spirit and fantastic to see such great participation from our students...
|

|
02 Dec 2025
We were delighted to celebrate all the students who completed their Bronze, Silver and Gold Duke of Edinburgh Awards at our awards evenings in November. These events have now become a fundamental part of our school calendar, giving us the chance to recognise the outstanding achievements of our young...
|

|
27 Nov 2025
We would like to thank all the visitors from a range of local businesses, providers and parents who supported us by acting as interviewers for our Year 11 Mock Interviews on Tuesday 25 November.
The event was an opportunity for us to provide all Year 11 students with the valuable experience...
|

|
27 Nov 2025
We are proud to announce that we have achieved the FairAware Award, recognising our commitment to learning about global issues and making informed, ethical choices. This award celebrates the hard work of our students and staff in understanding how everyday actions can impact communities around the w...
|
|
|
|
 |
08 Dec 2025
As we reach the end of another eventful half-term, it is a wonderful opportunity to reflect on and celebrate the progress our Year 7 students have made. They are now fully-fledged members of our school community—no longer needing help to find their way around or decipher their timetables, but...
|
|
|
 |
08 Dec 2025
Though I feel I always start these bulletins the same way, it is still true that it has been an incredibly busy half term for Year 8 at North Leamington School. The build up to Christmas is always a special time of year and it has been a real pleasure to see Year 8 throw themselves into all of the C...
|
|
|
 |
08 Dec 2025
This Autumn Term has evidenced the fantastic efforts that Year 9 are taking as they step up towards their GCSEs. Students have embraced the challenges of moving towards GCSE style grading in the CORE subjects and RE, and are beginning to think about the choices they will be making about their future...
|
|
|
 |
08 Dec 2025
We have been incredibly impressed with how positively Year 10 have begun their GCSE years. Students have continued this term with maturity, ambition, and a clear determination to succeed. Their focus in lessons, willingness to participate, and commitment to their studies have set a very st...
|
|
|
 |
08 Dec 2025
As we reach the end of another busy and productive half-term, it is an ideal opportunity to reflect upon and celebrate the progress our Year 11 students are making. With two full sets of mock exams completed, alongside Year 11 Subject Evening and the release of Data 1, students now have a clear unde...
|
|
|
 |
08 Dec 2025
I hope this update finds you well and you are looking forward to the upcoming festive season – it was great to see so many Year 13 parents at the recent Parent Evening and we look forward to seeing Year 12 on Monday 26 January 2026!
The first full term is drawing to a close (havi...
|
|
|
|
Well done to Binswood who have accumulated the most Reward Points for this half term, with Croft second and Blackdown third - both were very close.
Reward points start afresh again at the beginning of January - let see who tops the board for the next half term.

This half term has also seen the first College Fortnight with the second round of College Assemblies. These are an opportunity for all students to come together in their Colleges and help Year 7 feel even more established in their College families. It also saw the College Attendance Challenge, where we challenged each student to make their attendance count and achieve 100% during the week of 24 November. We are really proud of our students’ attendance which is well above the national average.
On this occasion, Park were victorious; congratulations to them and to all students working to improve and maintain their attendance in school.
|
|
|
|
Year 13 students have successfully completed Theme 1 and Theme 2 and have risen to the challenge of Theme 3: Decision-Making Techniques. This included developing skills in quantitative sales forecasting, investment appraisal, decision trees, and critical path analysis. In addition, students have been exploring Theme 4, with a particular focus on global mergers and takeovers. A key case study they looked at is Mars and its acquisition of Hotel Chocolat, which links effectively to the new Paper 3 context.
Students have also started detailed work on their Paper 3 pre-release topic: the confectionery industry. They are researching global trends, marketing strategies, and the impact of the industry on business growth, helping them build strong contextual knowledge for the exam.
Examples of their work exploring corporate culture and the classification of culture are below.




The November mock exam was also an opportunity for students to identify areas for further development and where support is required. Students have been able to work on identifying any gaps in knowledge and continuing to review revision resources.
Year 12 students have completed Theme 2, Raising Finance and Financial Planning. Students are developing their application skills through researching news articles and applying it to content learnt in lessons. It is imperative that all students complete revision resources, using chains of argument, key terms and practice questions from the Digital Learning Hub.
 We recommend all students purchase a copy of the Business Revision Guide and textbook - Pearson REVISE Edexcel AS/A level Business Revision Guide & Workbook: for home learning, 2022 and 2023 assessments and exams. We recommend all students purchase a copy of the Business Revision Guide and textbook - Pearson REVISE Edexcel AS/A level Business Revision Guide & Workbook: for home learning, 2022 and 2023 assessments and exams.
A Level intervention is in place every Tuesday & Wednesday from 3.15pm – 4pm.
Year 11 have started Topic 2.5 Making Human Resource decisions this half term. Interleaving and revision helped students to prepare for their recent mock exams and it is imperative that all students continue to update their revision resources for all topics covered in lessons. Students need to ensure they are completing practice questions to identify areas of development. Intervention is available every Thursday, 3.15pm – 4pm.
Year 10 have enjoyed learning about Topic 1.2 Spotting a Business Opportunity & Topic 1.3 Putting a Business Idea into Practice. Students have been researching sources of finance available for a business start-up.

It is imperative that all students complete revision and practice questions from the workbook to check understanding.
All students should have a copy of the Business Revision Guide and Workbook - Revise Edexcel Business Revision Guide
|
|
|
Digital Learning Hub (DLH)
All of our resources including teacher presentations, knowledge organisers, extension tasks, revision material, flash cards, curriculum overviews, exam papers, mark schemes, etc. can be found on the Digital Learning Hub (DLH) under ‘Computer Science’. This is a fantastic place to find materials to close any gaps in learning through absence or general revision for upcoming assessments, tests or exams.
Key Stage 3
Year 7 – What is a Computer?
This half term students have developed an understanding of the differences between input and output devices. Students have been able to recognise the key components that make up a computer and explain their functionality. Students gained an understanding of the function of the CPU and its relationship with RAM and the hard drive including the Fetch-Decode-Execute cycle.
Year 8 – Computer Control
Students have applied their learning of computational thinking to understand flowchart symbols and create algorithms in the form of flowcharts this term. Students have used specific software (e.g. Flowol) to apply their learning to create a series of algorithms that solve real life problems.
Year 9 – Python Programming
This half term students have revisited prior learning from Year 8 and developed their understanding and capabilities in using a high level programming language by exploring the use of input/output, selection and iteration.
Key Stage 4 - GCSE Computer Science
All of our GCSE students have continued to develop their programming skills using a high-level language (Python). In addition to this …
Year 10 – GCSE Computer Science
Students have been gaining an understanding of Primary and Secondary storage, the Binary Number System including how to convert from Binary to Denary to Hexadecimal (in any order), binary addition and binary shifts.
Next, students will be investigating how binary is used to represent characters, images and sound and also looking at file compression techniques and how they work.
Year 10 Additional Support
A reminder the curriculum overview, which can be found on the NLS website (scroll down to the bottom of the page) not only gives an overview of what topics are going to be taught but especially useful is the optional homework and literacy sections on the right. Here you can find many resources to guide your child so they can work more independently at home. I would highly recommend the Oak National Academy links which are created by teachers and are pretty much online tutors, there are lessons, videos and worksheets/activities to get engaged with plus the website links for NGfL and, in addition, Mission Encodeable, they are specifically designed to help with programming techniques and develop skills in an interactive way.
Please also encourage your child to regularly access their Revise:CSUK platform. This has been purchased for them to aid recall, develop their literacy of key terminology and exam question technique. Please aim to get them onto the quizzes for approximately 15-20mins each evening to build confidence.
Year 11 – GCSE Computer Science
Students have developed their understanding of how to ensure programs are robust including validation and verification techniques along with relevant testing strategies including black box, white box, alpha and beta testing. By the end of the term students will have touched on logic systems such as logic gates and Boolean logic. Next students will be studying the use of IDE’s including compilers and translators.
Students are continually encouraged to revise topics already covered in Year 10 via homework tasks and the use of the Smart Revise platform.
Year 11 Additional Support
A reminder of the support and additional work that can be completed at home for your child in their final year of GCSE Computer Science. Firstly, the curriculum overview which can be found on the NLS Website (scroll down to the bottom of the page) gives an overview of what topics are going to be taught but especially useful is the optional homework and literacy sections on the right. Here you can find many resources to guide your child to so they can work more independently at home. I would highly recommend the Oak National Academy links which are created by teachers and are pretty much online tutors, there are lessons, videos and worksheets/activities to get engaged. Secondly, the website links for NGfL and Mission Encodeable are specifically designed to help with programming techniques and develop skills in an interactive way, essential skills for paper 2 of the qualification. Lastly, please encourage your child to regularly access their Smart Revise and/or Revise CSUK platform. This has been purchased for them to aid recall, develop their literacy of key terminology and exam question technique. Please aim to get them onto the Advance section for approximately 15-20mins each evening to expose them to exam style questioning and build confidence.
Year 12 – A Level Computer Science
Students started the year learning about computational thinking methods including abstraction, decomposition, pattern recognition, thinking procedurally, thinking ahead, thinking logically and thinking concurrently and being able to apply these concepts to programming problems. Students have also learnt more about the CPU from GCSE including additional concepts such as pipelining, different architectures, types of processors, multicore and parallel systems, GPU’s and how all of these factors impact on the performance of a computer system. Following this, students have developed their understanding of software and software development methodologies. Next, students will learn about compression, encryption, hashing and database design before moving onto networks and web technologies.
Year 13 – A Level Computer Science
Students are finalising their programming projects which will be completed at the end of December. This element allows students to demonstrate their application of software development methods whilst giving students the freedom to express their creativity in solving a problem using computational thinking methods. Students are continually encouraged to revise topics already covered in Year 12 via homework tasks and the use of the Smart Revise platform. Next, students will be developing their understanding of any weaker areas of theory and getting ready for their final examinations.
Extra Support – GCSE and A Level
For all our GCSE & A Level students there is a continued promotion of using the Smart Revise platform (Years 11, 12 and 13) and Revise:CSUK (Year 10) to develop and enhance student’s ability to recall information and facts plus improve their use of literacy and keywords around the subject. Your support by encouraging your child to engage with this at home on a regular basis is much appreciated. Each student has their own personal login and can access the platform on any device through a web browser.
iDEA Award
 We encourage all students to at least complete the Bronze award for iDEA. This is something students can access at home as well as in class. Students have their own individual logins for these. We encourage all students to at least complete the Bronze award for iDEA. This is something students can access at home as well as in class. Students have their own individual logins for these.
These certificates are an invaluable addition to CV’s, references, College or University applications plus apprenticeships and are nationally recognised as evidence of IT literacy competency in the workplace.
Supporting Students At All Levels
We are currently promoting independence in computer science and have a variety of support mechanisms students can access during their lesson or even at home through the DLH. Some of these strategies are outlined in the image below:

Computing Literacy
The computer science department has a selection of fiction, non-fiction and coding books plus a range of revision guides available to loan from either the department itself or the school library to supplement homework and NLS literacy focus as a whole. We also have a large selection of computing magazines. We continue to add to this so, if you have any recommendations that you would like to see included, please email Mr Sycamore to add to the reading list. Some ideas to get started …

|
|
|
Year 7
Year 7 have continued to develop their collaboration skills working in groups. They have created a small performance exploring a genre of their choice and produced short group performances based on The Three Little Pigs, using Drama strategies such as Still Images, Narration, Thought-Tracking, Cross-cutting and Transitions.
Year 8
Year 8 have continued to develop collaboration skills and their ability to devise Drama in groups. Students have created pantomimes based on well-known stories such as: Jack and the Beanstalk, Cinderella, Snow White, Aladdin, Dick Whittington, Puss in Boots, Peter Pan and Hansel & Gretel.
These performances explored comedy skills inspired by Mischief Theatre (The Goes Wrong Show).
Year 9
Year 9 have focused on collaboration and effective group work. Students have explored an extract of text through a monologue, duologue or group performance, working either as performers or designers. They developed confidence by creating performances using a range of Drama strategies. Their final performance allowed them to interpret a script extract and experiment with appropriate techniques.
Year 10 GCSE Drama
Year 10 students continued working towards their devised performance, worth 40% of the final GCSE grade. Groups identified their performance intentions and took part in workshops exploring different practitioners’ methodologies.
Students will perform in the Spring Term and rehearse weekly as part of their homework.

Year 10 GCSE Drama students are looking forward to their Theatre Visit – Blood Brothers on Thursday 29 January 2026 at The Belgrade Theatre, Coventry.
More information is available from Drama teachers or via the letter distributed in September and available on the school website.
Year 11 GCSE Drama
Year 11 students have completed a mock exam this term. They revised for Component 3: Theatre Makers in Practice (Written Exam), focusing on:
- The study of one complete performance text (An Inspector Calls by J.B. Priestley)
- A live theatre evaluation (Romeo and Juliet)
Students continued revising Section A of the written exam. They were given an extract from the play and practised answering questions from the perspectives of:
- Performer (4-mark and 6-mark questions)
- Director (9-mark design focus and 12-mark performer focus)
- Designer (14-mark question)
Using checklists they identified revision targets, explored plot, characters and themes, and refined their Drama terminology for performer and designer responses. They also revised the play’s context—set in 1912 and first performed in 1945—and practised exam-style questions.
Students also revised Section B, improving their live theatre notes based on Romeo and Juliet and attempting further exam-style responses.
For homework this half term, Year 11 rehearsed for their Component 2 Performance Exam, scheduled for:
• Technical: Wednesday 4 March
• Exam: Friday 6 March
Vibe Drama Club Showcase
This term’s VIBE Drama Club was an exciting celebration of creativity and leadership. Led by our talented Year 9 Drama Leaders, they supported Year 7-10 students in developing their confidence and performance skills.
Throughout the term, they worked collaboratively to devise short performances inspired by well-known Christmas stories. Under the guidance of the Drama Leaders, they explored character, storytelling, and staging to bring these festive tales to life.
Their hard work culminated in a fantastic end-of-term VIBE Celebration Event, where the groups performed their pieces and demonstrated a wonderful display of teamwork, imagination and positivity.
Well done to all involved!
Rehearsal Club
Rehearsal Club has run every Thursday after school from 3.15–4.15pm to support students in developing their performance, design, directing and technical skills. Drama students have been encouraged to attend to rehearse coursework and assessment pieces, and the space is also open to those working on independent projects or audition preparation.
RSC Associate School Updates
 Four NLS students were selected as RSC Ambassadors and will attend a training event in Stratford-upon-Avon with an RSC Practitioner in the Spring Term. Four NLS students were selected as RSC Ambassadors and will attend a training event in Stratford-upon-Avon with an RSC Practitioner in the Spring Term.
This workshop will help them develop teamwork, leadership and communication skills as young people passionate about the Arts.
|
|
|
Year 7
Following last term’s work focusing on understanding villains, Year 7 have now taken up the challenge of creating their own wicked yet wonderful antagonists. From dangerous dictators and evil animals, they have begun to develop their descriptions skills such as building figurative language like similes and personification, adapting sentence starters to hook readers into their stories and varying their punctuation in writing for effect. They have been learning and applying these skills in classwork and we have seen some phenomenal villain-based home learning, from wanted posters for their chosen antagonists to creating their villain’s wardrobes. Developing their ongoing International Schools projects from last half term, students have been researching the bustling city of Mumbai in India through their homework, understanding the setting of our partner school so they can apply it to their upcoming villainous spy fiction stories.

At the end of this term, students begun to understand their classes spy, chosen by teachers earlier in the year and meet the villains created by our partner school in India. Using the skills they have developed from their story writing unit, they have successfully started to craft their narratives, focusing on the vital point where their classes spy and villain meet for the first time! We have seen some amazingly creative, insightful and enthusiastic responses and it is lovely to see how they can apply the skills we have worked on this half-term to a variety of tasks. Well done Year 7!
 
Year 8 have shown true empathy and sensibility this term crafting their persuasive speeches urging the UK government to do more to support vulnerable refugees, both in our country and across the world. Based on their prior learning last term from The Bone Sparrow and Refugee Boy, they have applied the themes of prejudice and discrimination explored with these key texts to express their own opinions and convince others to believe the same.
 Students have begun to explore the art of transactional writing through the key assessment objectives: language, structure and technical accuracy. Students have begun to explore the art of transactional writing through the key assessment objectives: language, structure and technical accuracy.
They have used persuasive techniques such as emotive language, statistics, triplets and facts to develop critical, clear and convincing speeches.
We have explored the significance of anecdotes to create a short, personal story provoking emotions from readers, cyclical structures to remind readers of a call to action and exploring ambitious vocabulary to create a sophisticated tone to their writing.
It has been so lovely to see such personal, heart-warming yet skill supported responses especially regarding such a politically-fuelled topic stemming from a real-world issue. They have done so with poise, responsibility and commitment to change and for those efforts, we are incredibly proud of the work produced.
Year 9
In their pre-GCSE year, Year 9 have focused on developing their transactional writing skills from Year 8, recapping their understanding of speeches and applying them to the integral themes of Frankenstein: science, experiments and morality. We have explored a number of case studies relating to both animal and human testing such as The Stanford Prison Experiment, Marius the Giraffe, Ralph and Rabbit, which have shocked, surprised and inspired some emotively-driven writing. To fully comprehend multiple perspectives, students have also been exposed to numerous articles from a range of different sources, allowing them to develop strong counter-arguments to further persuade those who disagree to convert their opinions, mastering the art of persuasion.


 Alongside revising the basics of language/structural elements of speech writing, students have experimented with higher level techniques such as cyclical and sentence structures, creating extended metaphors using semantic fields and applying higher level punctuation to adhere to the technical accuracy requirement of GCSE. Alongside revising the basics of language/structural elements of speech writing, students have experimented with higher level techniques such as cyclical and sentence structures, creating extended metaphors using semantic fields and applying higher level punctuation to adhere to the technical accuracy requirement of GCSE.
This has all been in preparing for our final assessment where students had to respond to a statement regarding the morality of science.
It has been so lovely to see students applying their new-found knowledge and skills, showing real engagement and enthusiasm for such controversial, sensitive and real-world problems.
Year 9 have this past week started to study this year’s Shakespeare play Romeo and Juliet, exploring the contextual ideas, understanding the nuances of language and beginning to comprehend the plot of the tragedy. We can’t wait to go back to our analytical language skills, especially exploring such a classic.
Year 10
Studying their second GCSE text, their first being An Inspector Calls at the end of KS3, Year 10 have gone back in time to the Victorian era, exploring either Jekyll and Hyde or A Christmas Carol as part of their 19th century requirement for the qualification.
With A Christmas Carol, students have explored themes of family, greed, Christmas and redemption through Scrooge’s journey, at the start of the novel being a ‘covetous old sinner’ to changing for the greater good by the end of the story, becoming a kind, generous Victorian gentleman who promises to “live in the past, the present and the future.” This heart-warming story has allowed students to develop their analytical writing skills from their previous GCSE study of An Inspector Calls, exploring writer’s methods, their effects, authorial intentions and contextual understanding to answer Literature Paper 1 style questions.
Similarly in Jekyll and Hyde, we have gone gothic, venturing into the dark depths of Victorian London, with questions raised regarding science, morality, good vs evil, reputations and duality of man. Through studying Stevenson’s mysterious tale, students have traced Dr. Jekyll’s unsettling transformation from a respected Victorian gentleman into the violent and morally corrupt Mr. Hyde, analysing how the novella exposes the dangers of repressing one’s darker impulses. This atmospheric and psychologically driven text has enabled students to strengthen their analytical writing skills developed during their study of An Inspector Calls, exploring the writer’s methods from symbolism and setting to narrative perspective, to unpick their effects and Stevenson’s wider authorial intentions. By engaging with the text’s rich contextual background, including Victorian anxieties about scientific advancement and societal respectability, students have practised crafting sophisticated responses for Literature, adhering to high levels of the assessment objectives.
Next term, Year 10’s will be exploring Shakespearean tragedies, either Macbeth or Romeo and Juliet, building on their knowledge from KS3 and their developing literature skills even further. This will be the final element of their Literature course, completing the Power and Conflict poetry cluster, 19th century text and An Inspector Calls already studied, so will be extremely exciting and a great opportunity to start some really effective revision later this year and into Year 11.

Year 11
Ahead of their mock exams Year 11 students have spent the term revising key texts from the Shakespeare and 19th century component for Paper 1 English Literature. Whether students are studying A Christmas Carol and Macbeth or Romeo and Juliet, they have explored the significance plot points, quotations, themes and context, adhering to the assessment objectives through their responses to create clear and convincing essays. We are driving home the theory of creating a ‘golden thread’ through analytical writing, developing strong thesis statement in order to successfully answer the exam’s given question.
 In support of the second mock, the latter half of the term focused on recapping the analytical reading and creative writing skills for Language Paper 1. In support of the second mock, the latter half of the term focused on recapping the analytical reading and creative writing skills for Language Paper 1.
The first half of the paper focuses on students analysing an unseen extract, zooming into language and structural choices to create effect on readers, as well as responding to and evaluating a statement regarding the source.
In preparation for their creative element, students have employed content and organisational techniques to craft effective descriptions and narratives as well as working on their technical accuracy.
Revision will start again in February every Thursday in the English department.
A-Level Literature
Year 12 Literature students have begun their study of the Love Through the Ages poetry anthology, exploring writers from Wyatt in the Tudor era all the way through to Rossetti in the Victorian period, considering how love is presented and how its nuances shift across time. We have delved into a range of literary movements, including carpe diem and memento mori, as well as exploring the work of the cavaliers and the metaphysical poets. This grounding has given students a strong sense of how ideas about love develop and reappear throughout literary history. In line with the AQA English Literature specification, students are developing their ability to analyse how writers’ methods shape meanings, explore wider contexts, and consider multiple interpretations—key skills that will underpin their success across the course. Next, we will be moving on to Fitzgerald’s much-loved novel The Great Gatsby, with the aim of guiding students towards producing detailed, comparative essays that draw meaningful connections between the poetry and the prose text.
Year 13 students have put their work into practice, completing their mock, Paper 1: Love through the Ages. Using the two set texts, writers must compare the novel with two poems from the cluster in reference to statements relating to all things romantic. Examples include ‘pain is a part of love’ and how ‘time affects relationships.’ Using evidence from their scope of texts, students have developed successful, critical and convincing responses adhering to the assessment objectives. For the rest of the term, our Year 13s have been reflecting on their examination techniques, delivering presentations on how they intend to implement their target AO’s, holding themselves accountable for development ahead of their summer exams.
A-Level Lang-Lit
Year 12 Lang–Lit students have made a strong and enthusiastic start. Through their Remembered Places Poetry Anthology, they have been transported into the heart of Paris, exploring how writers capture a sense of place, people and memory. They have begun applying the analytical skills built at GCSE to this more advanced level, comparing texts, considering different viewpoints and thinking carefully about how context shapes meaning. Engaging with a wide range of poetic voices—some nostalgic, others challenging—they have produced thoughtful and detailed responses that show real promise. Students are building the confidence, independence and curiosity that will support their progress over the next two years.
Year 13 students have been working on their NEA recast writing based on their study of Hosseini’s The Kite Runner. This allowed them to immerse themselves creatively in the text, transforming an element of the original narrative into a new form, voice or perspective while still capturing its core themes and intentions. Students have carefully crafted their recasts with close attention to characterisation, narrative style and context, ensuring their writing feels authentic and purposeful. Alongside this, they have developed detailed commentaries that explain and justify their creative choices, demonstrating a strong understanding of both the source material and the assessment objectives. Through this students are honing their independence, technical accuracy and analytical sophistication—key skills that will support them as they move towards the final stages of their A-Level course.

|
|
|
Year 10 Media students have been exploring both Component 1: Exploring Media Language and Representation as well as crafting a mock-up of Component 3: Creating Media Products. Both components work hand in hand for students to understand choices that media professionals make and emulating similar decision in their own work for consumer effect. Whilst exploring magazine covers such as Malala’s Vogue and Raheem Stirling’s GQ, students have analysed colour, composition and shot types and how they can craft meaning and effect, specifically with focus on representation of gender, race and religion. In their coursework lessons, students have been getting to grips with design software including Adobe’s InDesign and Photoshop to produce convincing, creative and effective DVD covers for action films, exploring the structure of this media and looking at the key components for success: titles, blurbs, original photos, cast lists etc. This will prove essential knowledge and skills when it comes to crafting their assessed coursework, starting in the Spring/Summer term.
Year 11 prepared for their mock exam, the paper focused on the way in which Media Language and Representation are used in a clip from the BBC crime drama, ‘Luther’ with students writing about the way costume, setting and props are used to portray ideas within the genre, communicating effectively with their audience. They also looked at how the music videos for Justin Bieber’s Intentions and Taylor Swift’s The Man represent marginalised groups. After Christmas, Year 11 will be receiving feedback on their NEAs. For these NEAs, Year 11 created a DVD cover and film poster for a film of their devising but that fulfilled an audience’s expectations in the action genre. It is incredibly interesting to see the diversity of their imaginations, and we look forward to giving them feedback on these, once they have been assessed.
A Level Media
For our Year 13 Media students, NEAs have been the predominant focus for much of the half-term, with students handing in their largely successful first drafts in November. For this task, they have been creating cross-media productions centred on either Magazines, Music Marketing, Film Marketing or Television, with each student then producing a corresponding piece in an alternative media format. This process has allowed them to demonstrate both creativity and technical skill, applying key media theory while making purposeful decisions about audience, representation and industry conventions. Students have shown real commitment in developing polished, professional-looking products, and as they move into the refinement stage, they are now preparing to reflect on feedback after Christmas, strengthening their practical work and preparing for their final NEA submissions later in the year.
|
|
|
Year 7 have been developing their knowledge of the British Isles as well as key Geographical skills such as map skills in a topic called “Is Britain Still Beautiful?” Next term they will be exploring places on a more global scale such as coral reefs.
Year 8 are coming towards the end of a topic called “Why are we not all equally rich”? this topic explored key development issues in the world.
Year 9 have explored biomes of the world, both the physical and human geography features within them, in particular tropical rainforests and deserts.
At Key Stage 4 Year 10 have completed their first topic for GCSE Geography called “The challenge of natural hazards”, where hazards such as earthquakes and tropical storms have been investigated.
In Year 11 a key focus has been on fieldwork skills and on November 17 we went to Birmingham city centre. Here, students investigated the opportunities that urban regeneration has brought to the city. Four sites across the city were explored including Brindley Place, the Library, Grand Central Station and we ended our day in the Bullring. All students represented NLS fantastically and carried out their fieldwork in a very sensible way, many also carried out questionnaires with members of the public and it was great to see their confidence grow to carry these out!
At Key Stage 5, Year 13 have been busy completing their NEA based on a summer field visit to the coastal town of Southwold and have been spending lesson time studying two very topical topics - Human Rights and Migration. Recently they moved onto a topic on hazards and a topic called Earths Life Support systems.
Year 12 have been continuing to cover two topics on coastal landscapes as well as investigating changes in places.
|
|
|
Year 11 Travel and Tourism students have recently completed their non-exam assessment work for Component 2, Customer needs in Travel and Tourism (worth 30% of overall grade). This involved completing five tasks ranging from planning a business holiday to Northumberland to evaluating how effectively different UK airports support the needs of younger and older children. They have now moved onto study Component 3; Influences on Global Travel and Tourism. This will be a unit examined in the summer term (worth 40% of total marks.)
|
|
|
Year 10 Health and Social Care
Students have been working hard this half term exploring how different factors can affect individual’s development across the life stages, from infancy to later adulthood. They have covered how factors such as low income, bereavement, and pollution can affect a person’s development and much more!
They have completed assessments for two of the tasks on human life stages & factors that can impact health and wellbeing and will also complete for their coursework which will start in February 2026. They are beginning to use specialist terminology and explaining the differences and similarities experienced between individuals at different life stages. At the start of January, students will begin to look at life events that can affect how we develop, such as marriage, imprisonment and injuries.
Year 11 have completed their second component of coursework ‘Health and Social Care Services and Values’ which comprised of five written tasks and equated to the next 30% of their BTEC course. Students have been incredible completing this coursework with excellent attendance to intervention and all going the extra mile. Students will receive the results of Component 2 in March ahead of their examination unit. For the final term, students will be completing Component 3 ‘Health and Wellbeing’ where they will be working through three learning aims to prepare for this exam. The knowledge they will be developing and re-visiting is how factors affect health and wellbeing, health indicators and person centred care. This will provide students with the knowledge and understand to not only assess what is impacting an individual's health and wellbeing but also how to support recovery. The transferable skills from this examination unit will be invaluable for those students considering a career in a Health and Social Care sector or pursuing the level 3 qualification at A level.
Year 12 students have completed their study of the remaining life stages within Unit 1: Human Lifespan Development and explored middle adulthood, late adulthood, and later adulthood, examining how individuals experience physical, intellectual, emotional, and social development during these periods. Students considered changes such as age-related physical decline, continued intellectual growth through lifelong learning, emotional adjustments linked to life events, and the evolution of social roles and relationships.
Students have begun Learning Aim B, focusing on the factors that influence human development. Recent lessons have examined the impact of drug and alcohol use, physical exercise, and other lifestyle choices on overall development.
In addition, students have made an excellent start on their independent homework research into health and social care professionals. So far, they have explored the roles of general practitioners, psychologists, counsellors, and several other key professionals within the sector.
During this week, students completed their first major assessment for Unit 1, the End of Term Assessment. They will receive detailed feedback on their performance after the Christmas holiday.
Our cohort of Year 13 Health and Social Care students are already over halfway through the teaching of their examination unit. They completed a full paper in their mocks, with strong results that stand them in good stead for the summer examination. Unit 2 is worth 33% of their final grade, with one examination already completed as well as two pieces of coursework.Students have been reflecting on their progress and have clear actions and topics they are focusing on, both individually and as a group.
They will have a further practise in January before another full paper in February in the next mock examination window. We are on track to complete the teaching of the course before the Easter holidays, allowing additional time for revision within lessons. Students can continuously improve and develop their revision resources and are very happy to be quizzed on these at home!
We always appreciate your support in preparing students for their exams. Alongside this, the students are also working well on their coursework element and are well on track to finish. Don’t forget to look at the optional reading and watching section on the ‘Curriculum Overview’ on the website– some interesting, topical and very useful reviews of their learning that is accessible for all and provides some interesting options for debate at home/with friends!
|
|
|
Year 7 have studied William the Conqueror’s consolidation of power this term. We then looked at life in the medieval world, with a focus on the most interesting events, including the fraught relationship between Henry II and Thomas Becket culminating in his murder in Canterbury Cathedral. We also looked at the importance of religion to the medieval mind, the Black Death and its de-stabilising effect on medieval society, leading to the Peasants Revolt. We will go onto to look at King John and the restraint Magna Carta placed on the power of medieval kings after Christmas.
Year 8 continued their focus on the Tudors and Stuarts. This included the challenges to Elizabeth I, including the Spanish Armada, and the ill-fated Stuarts and their role in the English Civil War, ending with the execution of Charles I. We then focused on Oliver Cromwell and the Interregnum, which ended with the return of Charles II in 1660.
Year 9 completed their focus on the First World War this term. After Christmas we will move onto World War II which will begin with an assessed piece of work on the causes of World War II and the role played by the British government’s appeasement policy. We then cherry pick the most interesting aspects of World War II, including evacuation, whether the retreat from Dunkirk was a triumph or a disaster and the Blitz. Please look out for a research homework project asking students to research their family’s involvement in World War II. We will also examine the Holocaust and the arguments for and against the bombing of Dresden and the first and only use of atomic weapons to end the war in the pacific.
Year 10 have continued to work through paper 1 of their GCSE this year. We are currently looking at Medicine from 1900 to the present, including lung cancer as a case study. Next term we begin Early Elizabethan England, which is the first half of paper 2, the second half being International Relations and the Cold War.
For those History GCSE students signed up to the Battlefields Trip in 2026, please be aware of the payment schedule you have received.
Year 11 have been working their way through the politically and economically turbulent post-WWI period in Germany, leading to the rise to power of Hitler and the Nazi Party. Year 11 have completed a full paper 2 mock exam this month – Elizabeth I and the Cold War. We hope the schedule given to support their revision was helpful. They will be given another revision schedule focused on paper 1 when we return in January. If you are yet to do so, we recommend you purchase a revision book to support with this. Please contact your child’s History teacher if you have any concerns or need any support with revision.
Year 12 historians are working through paper 1 and 2 – Britain, 1918-97 and the USA, 1955-92 – which is their focus for the year.
Year 13 historians have started paper 3 – the British Experience of warfare – and have been working hard on their coursework with the first draft submitted before the end of term.
|
|
|
Year 12 Politics students are working through paper 1 and 2 – British Politics and British Government – which is their focus for the year. It is important that students keep abreast of contemporary political events by reading broadsheet newspapers, following politics programmes on TV and radio and listening to the podcasts that have been suggested to them in class.
The same applies to year 13 which will enable them to comment on contemporary events in their June exams. They will also need to follow global political events which is the focus for their paper 3
|
|
|
Year 7
Students have settled wonderfully into their new maths groups and have made great progress so far this term. We have really enjoyed diving into key topics, including working with decimals, introductory algebra, and negative numbers.
We launched SPARX Maths with the year group in November, and it has been incredibly successful. We are delighted that many of our students are enthusiastically using the independent learning feature to practice and extend their skills. The Maths department runs a SPARX Maths Clinic every Thursday in S216 from 15:15 to 16:00. Students can come to these sessions to either complete or get support with their SPARX homework.
The Maths department also runs a Maths Club on Thursdays after school for our year 7s, where students get to solve fun problems, do rich tasks, and explore the wonderful world of Mathematics. Students are strongly encouraged to give it a go.
We have started giving our students weekly Maths Challenge questions, which they are loving! One participating student will win a £10 Amazon voucher weekly. At the end of each half-term, all previous winners go into a pot for a £20 Amazon voucher prize.
Finally, a reminder that our Maths Homework Space is open every Tuesday from 15:15 to 16:00 in S206. This is a great, structured opportunity for students to get support and stay on top of their learning.
Year 8
Year 8 students have had a fantastic term, successfully covering key topics such as number theory, sequences, angles, and probability. We are very excited about the upcoming parents' evening next term, where we can discuss the fantastic progress the year group has made so far.
The use of SPARX Maths goes from strength to strength. We are convinced that the regular homework completed, along with the extra hours students dedicate to the independent learning feature, is significantly contributing to their progress. To support this further, the Maths department runs a SPARX Maths Clinic every Thursday in S216 from 15:15 to 16:00. Students can attend these sessions to complete or get support with their SPARX homework.
The Maths department also runs a Maths Club on Thursdays after school for our Year 8s, where students get to solve fun problems, do rich tasks, and explore the wonderful world of Mathematics. Students are strongly encouraged to give it a go.
We have started giving our students weekly Maths Challenge questions, which they are loving! One participating student will win a £10 Amazon voucher weekly. At the end of each half-term, all previous winners go into a pot for a £20 Amazon voucher prize.
Finally, a reminder that our Maths Homework Space is open every Tuesday from 3:15 PM to 4:00 PM in S206. This is a great, structured opportunity for students to access support and stay on top of their learning.
Year 9
Year 9 students continue to make good progress in their Maths lessons. Students have completed two GCSE modules to date: Module 1 on Number and Module 2 on Geometry and Angles. The modules are now longer in content with new knowledge and skills being introduced. Students are currently working on Module 3 Fractions, Decimals and Percentages. This module continues to develop the work they have completed on these areas at KS2 and 3. Students should be encouraged to complete all Maths homework which is set weekly. Additionally, students should begin to get into good revision habits, using their personalised learning checklists that can be found on the front page of their Module 1 and Module 2 assessment to begin to fill any gaps in knowledge identified here. Their resilience has been amazing, and progress is looking very promising! We’re super impressed with their engagement and participation!
Year 10
Year 10 students have been working hard this term and completed Module 9 and 10. Module 9 focusses on Mensuration Calculations, involving skills such as perimeter, area and volume as well as Trigonometry. Module 10 is an Equations and Inequalities module that builds upon skills taught in KS3 and develops these skills further into GCSE. Teachers and students have worked hard on revision strategies and techniques in lessons to ensure students are fully prepared for their module assessments. They have started Module 11 which covers Ration and Proportion skills. At home, please encourage students to complete their weekly homework to the best of their ability as well revision to fill any gaps identified in previous assessments. Students have a personalised learning checklist for each module that can be found on the front page of their assessments. They have identified areas for improvement and should dedicate time at home, little and often, to complete revision on these areas. Students can use websites such as Maths Genie and Corbett Maths as well as the Digital Learning Hub to help support their revision.
Year 11
Year 11 have been putting in an excellent effort this year in maths! We achieved really encouraging mock results in October and we are now all working towards the second mock in February – this one will have all three papers (one non-calculator and two calculator).
When students received their last mock they received a PLC (Personal Learning Checklist) with a list of all the topics in the mock. They were all advised by their maths teachers to highlight about 10-15 topics they got wrong. These topics need to be worked on in future. All students should use the website Maths Genie or Corbett Maths to close these gaps in learning for about one hour a week.
In the new year we will be running after-school maths revision sessions on Tuesday after school. Students are strongly encouraged to attend.
We have completed the course and so all maths lessons are effectively going over key topics. We will, as we get closer to the third mock in February and the final exams, complete many more practice papers – students should attempt as many exam questions as possible to familiarise themselves with the sort of questions to expect.
Year 12 have made a strong start to the course with most students on track to meet their demanding target grades, showing that their hard work is paying off. They have been studying calculus, the first pure topic that isn’t covered in some way at GCSE, as well as more advanced probability. The Further Mathematicians have adapted really well to the additional demands of this course and are also showing great promise!
We had the support of some year 12 volunteers during Sixth Form Open Evening. We would like to thank them all for giving up their time to help us, contributing to a very successful evening overall with lots of interest in Maths A level going forward.
Looking to the future, all Year 12 mathematicians are hard at work preparing for their first mocks in February, which will give a much better picture of how much they have learnt over the year. We are confident that if they maintain their work ethic they will do very well!
Year 13 are adapting well to the jump in difficulty from AS level maths to full A level content. They have now covered all of the Statistics content for the course. They are also spending lots of time looking back over topics they may have found a bit trickier from their recent mock papers, using their personalised learning checklists to help them, as well as covering more advanced calculus in lessons. Over the coming months they will also be receiving a greater amount of past papers to practise exam style questions.
In Further Maths, the class are practising advanced level questions to help with university entrance papers, and will be spending a lot of time revising content as most of the course content has now been delivered.
|
|
|
 French French
Year 7
Well done to year 7 who have completed their first full set of assessments this term. They all did incredibly well with lots achieving their target band or above in their speaking and reading tests. Students have been getting more confident each week with their language skills and can construct full sentences, respond to question and give opinions and justifications. We have just started our second module - the school topic, which we are looking forward to continuing after the Christmas Holidays. Joyeux Noël!
Year 8
Year 8 have worked hard all term and their results from their writing and listening assessments are testament to this. Students have learnt how to describe their family in detail, where they live, what they eat for breakfast and what pets they have. Students have recently started their second unit and have so far covered places in town and how to describe weekend plans and use the irregular verb aller. This unit will continue after a well-deserved Christmas break. Joyeux Noël!
Year 9
Year 9 students successfully completed their speaking assessments this term and have produced some fantastic results. This was their first experience of completing a GCSE-style task and required students to plan and revise very carefully. Now that the festivals topic is completed, students have started their digital technology module. In the lead up to the Christmas break, students learnt TV genres, used qualifiers to develop their opinions and justifications, and learnt how to construct questions in French. Well done year 9, you have all worked very hard this term and should be proud. Joyeux Noël!
Year 10
Year 10 students have rapidly made their way through the first two GCSE modules this term and have just finished Module 2 – Mon clan, ma tribu –, which has looked at personal identity, physical descriptions, family relationships, reflexive verbs and celebrations. Students finished the term by completing a listening assessment – maybe not the most Christmassy way to end a term but their excellent results definitely reflect their hard work and dedication this term. We look forward to beginning our third unit after the Christmas holidays. Joyeux Noël!
Year 11
In the last few weeks, Year 11 students have made good progress through the environment module. They are confident discussing local and global environmental issues and what they can do to help the environment. They have finished the autumn term by completing their first full set of French mocks. All students have worked tirelessly throughout this term and have demonstrated their hard work and dedication in this set of mock exams. No doubt, their results in January will be testament to this. We look forward to welcoming students back in January for our last few modules before beginning the revision process. Joyeux Noël!
 German German
Well done Year 7 German students. They have continued to make fantastic progress, and we were extremely pleased with the results from the speaking and reading assessments this term. Our students used different strategies to help them with learning vocabulary and they created revision flashcards to support their learning. They also studied the topic of describing pets, and have become confident with written skills. We have looked at Christmas in Germany and learnt about the traditions, the similarities and the differences.
Year 8 German students have worked extremely well on the topics of places in the town, shopping for souvenirs and snacks. We hope one day to visit Germany to put all this vocabulary to good practice and in real-life situations. Students have been really enthusiastic with the role plays we have composed in class and their pronunciation of German is spot on. We were so happy with the results from the listening assessment and the writing test. Our students have made excellent efforts with learning vocabulary and grammatical structures in preparation for these assessments. Well done!
Well done to our Year 9 students. They have been really motivated studying the topic of food and drink. We have looked and drooled over many delicious German foods, including Flammkuchen. Some were even very keen to go home, find the recipe and try it out themselves. Mmm lecker! They completed an assessment in both speaking and reading. The pronunciation of German phonics was excellent and were able to use present tense verbs and past tense examples. They have spent time revising for the reading test and their results were fantastic. Well done Year 9! Continue with the great progress and we hope they are considering GCSE German next year.
Year 10 students have studied the topics of music and film, free-time activities and arranging to go out. They particularly enjoyed a German song about Hawaiian Toast by Alexander Marcus. Kitschig! We have been so pleased with their attitude to learning, the fantastic questions they have asked about German and how they have all supported each other. Year 10 have listened extremely well to feedback and have made excellent progress. The results for both the speaking and reading assessments were extremely pleasing. Their hard work has really paid off. We are looking forward to seeing them progress even further.
Well done to Year 11 German students. They have recently completed their progress tests in Listening, Reading and Writing. This term, we have studied the topic of holiday and have been so impressed by their attitude to learning and their standard of German. They have referred back to the feedback from the Speaking mock and have included a whole range of higher-level (TAILORED) structures to the holiday theme. We hope that they are considering A-Level German, as there is real ability in the Year 11 groups.
Frohe Weihnachten und ein glückliches Neues Jahr!
|
|
|
Year 7: Expression in Music & Pitch in Music
Expression
This unit of work has focused on music appreciation, composition and sequencing, exploring the use of musical devices to create ‘expression’ in music. Students have been provided with listening tasks to develop their understanding of how musical elements can be applied to enhance a story. Students were tasked with using music software to compose a musical soundtrack for a fairy tale to enhance the action, drama and emotion in the narrated text. Students have begun to develop their musical sequencing and editing skills alongside elements of composition and theory.
Pitch
This unit of work has focused on performing written music. Students have developed their practical music-making and keyboard skills alongside their understanding of pitch. Notated music has challenged students to consider note placement and pitch to reproduce famous musical melodies, whilst developing their keyboard and collaborative skills. Students are encouraged to perform to the class for assessments and build confidence through shared music-making experiences. Resources have been provided to offer students of all musical ability the opportunity to access the curriculum and develop musical understanding.
Year 8: Winter Story
This unit of work has focused on music appreciation, composition and sequencing, exploring the use of musical devices to create ‘expression’ in music. Students were provided with listening tasks, including programme music, to develop their understanding of how musical elements can be applied to enhance a story. Students were then tasked with using music software to compose a musical soundtrack for a ‘Winter Story’ to enhance the action, drama and emotion in the narrated text. Students have continued to refine their musical sequencing and editing skills alongside elements of composition and theory.
Year 8: History of Pop
This unit of work has focused on music appreciation, listening, analysis and performance. We have listened to music from the 60s, 70s, 80s and 90s focusing on artists such as the Beatles, Queen, Madonna, The Spice Girls and Blur. Students have been tasked with performing a selection of popular pieces to reflect their understanding and appreciation of musical styles and sounds from the past. The combination of historical, contextual and practical tasks has given students the opportunity to engage with artists and genres that continue to influence the popular music of today.
Year 9: Game and Film Music
Performing/Composing/Sequencing
This unit of work has focused on students collaborating in pairs or small groups to compose and produce a soundtrack for film. Students use sequencing software to edit film and reproduce a soundtrack, including special effects and music. Students are encouraged to analyse film music, through listening tasks to gain an understanding of key terms and musical devices used to create a film soundtrack. Students have been guided to focus on detail and compose original ideas to refine their sequencing and music-making skills.
Performing
This unit of work has focused on students collaborating in pairs or small groups to perform a chosen film or game soundtrack. Students have been encouraged to develop their practical, technical and collaborative performance skills, practising and performing challenging notated music. They were also encouraged to consider the film/game genre and apply genre-specific stylistic or musical features to their performance. Students have been guided to demonstrate a disciplined approach, review their work, monitor progress and identify areas for development.
Year 10: BTEC Music Level 2: Component 1
Students are currently preparing for Component 1 and 2 of their course. During these components, students learn about a range of musical styles and tasked with performing, reproducing and composing pieces to demonstrate their practical/instrumental/music-making skills. Alongside their practical work, students produce written analysis and reviews to demonstrate their historical, contextual and theoretical knowledge.
Year 11: BTEC Music Level 2: Component 2
Students are completing their PSA for Component 2. This unit is focused on students developing and demonstrating their music composing skills using a combination of music software tools, live techniques and instrumental skills to explore, compose and realise their creative ideas. They are composing music to reflect the theme of Celebration, providing written analysis/reviews to record their progress and demonstrate their knowledge.
Year 12: BTEC Music Level 3: Unit 1
Students in Year 12 are developing their knowledge of music theory by completing performing and composing tasks. They continue to build on their current understanding of western musical traditions and notation with a view to consolidating their knowledge in the form of a presentation and musical examples for assessment in January 2025.
Year 13: BTEC Music Level 3: Unit 6
Year 13 have recently performed a short programme of solo music. They performed their music in a 30-minute recital for an upcoming assessment. They are also collaborating with other musicians to develop a musical ensemble and set of music to be performed at upcoming events.
Extra-Curricular
- Orchestra: Tuesdays 3:30pm – 4:30pm
- Rock Club: Wednesdays 3:20pm – 4:20pm
- Steel Band: Wednesdays 3:30pm – 4:30pm
- Pop Choir: Thursdays 3:30pm – 4:30pm
There are a variety of extra-curricular music opportunities on offer at NLS. A number of KS3 students were given a music-making opportunity to rehearse and perform in a large orchestral ensemble with students from other schools.
The Secondary Come and Play morning at Oakley School arranged by Warwickshire Music was a real success and the NLS students were excellent ambassadors for the school and music department.

Many of our musical groups and soloists have recently performed at our annual Winter Concert.
The evening showcased our talented students performing a variety of winter-themed pieces, in a wide variety of acts ranging from solo performers through to our large ensembles, Pop Choir, Steel Pans and making their debut our new NLS School Orchestra.


Students from each year group were represented and created a sense of unity and celebration of the hard work and dedication of our young musicians.
The programme featured a rich mix of genres including those students have studied in lessons such as Rock and Roll Music, classical music pieces such as Debussy’s Arabesque performed by Amelie on the piano and two stunning solos, I Dreamed a Dream from Emily and Once upon a December from Clea.
The concert also included several band items with some classic pop pieces such as Don’t Look Back In Anger and Supersonic by Oasis.
|
|
|
In lessons, Year 11 GCSE PE students have completed their mock exams and the coursework element of the course before having their practical performances assessed when they return in the new year.
A-level students have also faced mock exams in the final run in towards their summer exams.
Year 11 BTEC Sport students have been covering the course content in preparation for their exam.
Year 10 BTEC Sport students have been completing their first formal assessments during lessons.
Our Year 11 BTEC Dance students have made excellent progress this term and have now successfully completed 60% of their course. As they move into the final stage of their BTEC Dance course, students will be focusing on the choreography component, which forms a significant part of their final grade. This is a crucial period, and we are encouraging all students to maintain their strong work ethic, attend all lessons, and continue giving their best effort. With continued commitment and support, we are confident they will finish the course to a high standard. Well done Year 11!
 Our Year 10 BTEC Dance students have made a fantastic start to the course and are already showing great enthusiasm and professionalism—helped by their new BTEC Dance T-shirts, which they are wearing with pride. Our Year 10 BTEC Dance students have made a fantastic start to the course and are already showing great enthusiasm and professionalism—helped by their new BTEC Dance T-shirts, which they are wearing with pride.
Students have been working on the first 30% of their assessment for Component 2, developing key performance skills and building confidence in class. Following the workshop opportunity with Harrison from Motionhouse dance company last term, students are building from this great experience in their learning of All That Jazz from Chicago the Musical. Their progress so far has been excellent. There will be an opportunity to see them perform this piece in March 2026 at the Dance recital, where their hard work and dedication will be showcased on stage.
Our Core PE lessons have seen students taking part in Football, Rugby, Basketball, Badminton, Health related Fitness, Dance and Table Tennis.
Despite the dark and cold nights drawing in, it continues to be a busy time in PE. Extra-curricular clubs and fixtures have continued with Football, Basketball, Netball, Hockey, Dance and Rugby. Highlights include:
Football
The Year 7 Girls Football team took part in a 5-a-side indoor tournament at Myton and showed great promise. With short games the pressure was on to take chances that came their way as one goal could be enough for a win. The team found this out to their cost when despite having countless chances against a strong Campion side, they conceded their only shot on goal and lost 1 -0. They bounced back well though and dominated the next three games, coming away with comfortable wins against Kenilworth, Kingsley, Myton, before they were held to a draw in their final match against Southam when Southam scored in the last minute.
The Year 8 Football team travelled to Oakley for a District Cup fixture, the competition they are defending champions. With the Year 8 Rugby team playing the same night and some being part of both teams, it gave NLS the chance to demonstrate their strength in depth by giving some other pupils a chance to represent the school. In came Leo, Leylan and Nathaniel and they did not look out of place as they helped NLS dominate play from start to finish, playing some lovely flowing football throughout the match.
NLS finished 7-0 winners with goals from Nathaniel, Rajan, Toby and Rafe to go along with a hat- trick from Captain Leo. Well played to all the boys who progress a step closer to defending the Cup.
The Year 11 Football team welcomed Aylesford to NLS for a League match under the lights on the astro. In a tight game, clear chances were few and far between as two-evenly matched teams cancelled each other out. NLS probably just edged it but couldn’t take their chances and the game finished with fair 0–0 draw.
Basketball
The football season generally makes way for the Basketball season and the Year 7 and 8 Basketball teams have started with a couple of central venue competitions.
The Year 8 team travelled to Southam and then Myton to take part in three matches on each occasion with all results going through to a league format, with the top two teams going on to face each other in a longer final, later in the season. The Year 8 team went undefeated last year and continued where they left off with convincing wins in all of their six games. NLS will host the next three central venue meeting in the New Year and also begin their Junior NBA campaign as they compete in a Midland wide competition.
The year 7 Basketball also took part in two central venue competitions, showing promise for the future. Despite not featuring any players that are playing outside of school, which many of the other schools were lucky enough to have, the NLS boys did extremely well, coming away with three wins, two draws and three losses in the games, but that included a superb win against the previously undefeated Myton team. The boys will hope to improve their record when they take part in the third meeting in the new year.
The Year 9 Basketball team welcomed Campion over for their first game of the season. With a number of players missing due to injury and illness, they had two year 8s step in to support. It was a tight game from start to finish with a number of lead changes throughout, but in the end it was Campion's vastly superior height advantage which saw them over the line 42-38 despite the best efforts of NLS leading scorers Rory and Zach.
Rugby
NLS have organised a number of central venue Rugby fixtures in an attempt to get more schools playing Rugby, this allowed the year 7 rugby team to have their very first rugby tournament at Leamington RFC, in which they did extremely well.
The team played a strong Stratford team first. We played well, the tackling was fantastic and so was their attacking play. Stratford were really good over the ball and kept turning the ball over to be two tries to 0 at half time. The second half started with some strong carries by Leo and skipper Ralphie to being the scores level 2-2. In the final minutes of the game Stratford went over in the corner to win it.
Game two against Myton was a good match; the NLS boys ran with great strength and determination making breaks and offloading to the tryline, top tackler award goes to Ralphie. The tries came through some well-executed passing and running lines to make the game 5-1 win NLS . A great fixture!
The year 8 Rugby team welcomed Kenilworth and Myton to a similar central venue Rugby meeting. NLS got off to a storming start, behind excellent team defence and some sweeping attacking moves let by Dan, Callum and Max and ran out with a 6 tries to 1 victory. In their second game against a well-drilled Kenilworth team, it was the domination in the rucks, led by Jude, Joseph and William, that gave the attack, led by leading try scorer Max, the platform to run out 3–0 winners. Well done boys.
Netball
NLS Netball teams across all year groups have had a fantastic start to the season and their respective league campaigns. Their enthusiasm, commitment, and teamwork have been consistently impressive, and it has been wonderful to see so many students representing the school with pride.
Year 7 made an excellent start to their netball journey, securing three strong wins and only narrowly missing out in their final fixture against Myton. The team have demonstrated great potential and promising development in their first competitive season.
Year 8 are unbeaten so far after four matches. Their confidence, determination, and tactical understanding have grown with each match, resulting in their well-deserved undefeated record.
Year 9 continue to build on their success from previous years and are unbeaten in the league, with three wins and only Kingsley left to play in the new year. They also achieved a notable cup win and represented the school in a challenging county tournament. Despite facing exceptionally strong and well-drilled opposition, the girls showed outstanding resilience, learnt valuable lessons, and rose to the challenge with maturity and teamwork.
Year 10 have also enjoyed a strong start to the season, recording two wins and one narrow loss. They, too, will face Kingsley in the new year as they continue their league campaign.
Our B Teams have also made positive starts, with the Year 9B team achieving victories in friendly fixtures against Kenilworth and Heart of England. Additional fixtures for the Year 7, Year 8, and Year 9 are arranged for the new year to give even more students the opportunity to represent NLS.
We look forward to seeing you all in the new year for more excellent netball.
Cross Country
Following impressive performances at the Warwickshire Schools inter-schools Cross Country event in Stratford, a number of NLS students were selected to represent Warwickshire at the inter-county meeting in Dudley recently.
- Freddie F & Amelia F - year 7
- Lola G & Zach S - year 9
- Dylan K - year 10
- Jacob S - year 11
Dylan and Jacob helped the Warwickshire senior boys win first place in the inter-counties competition. Well done to all those who represented the county.

Trampolining
 Another student who has been competing and performing extremely well is Joshua BB. Josh has been competing in a number of high-level Trampolining Competitions and won a gold medal in November at the West Midlands Regional Trampolining Championship before following with another first place in the BSGA West Midland Schools Regional Championship. Another student who has been competing and performing extremely well is Joshua BB. Josh has been competing in a number of high-level Trampolining Competitions and won a gold medal in November at the West Midlands Regional Trampolining Championship before following with another first place in the BSGA West Midland Schools Regional Championship.
Well done Joshua!
|
|
|
Year 7:
Our Year 7 students have been looking at what it means to be British and exploring our British values including; democracy, rule of law, individual liberty and respect and tolerance of different faiths and beliefs.
Year 8:
Year 8 students have been have been looking at transferable skills this half term. We have seen some great examples of team work and communication as students worked in small groups and competed to build the biggest towers in lessons. Well done Year 8!
Year 9:
Year 9 have been looking at workplace and enterprise skills and career pathways. They have been reflecting on their own skills and interests to help them prepare for choosing their options later this year.
Year 10:
Year 10 have been looking at financial issues and have been developing their understanding of credit and debit cards and consumer rights so if you need to return anything after Christmas they will be able to tell you all about your rights of return!
Year 11:
As part of our relationships unit, Year 11 have explored the potential challenges of becoming a young parent and we have examined issues surrounding pregnancy and fertility, forced marriage and honour based abuse. Students have shown a great deal of maturity and we have been impressed by their willingness to ask questions.
Year 12:
As part of our living in the wider world unit Year 12 have been looking at exploring options available to them after A-levels, including university, gaps years and entering the world of work. Students have discussed and reflected on the potential pros and cons of each option for young people depending on their interests and circumstances.
Year 13:
Year 13 have been exploring issues relating to healthy relationships including positive communication in relationships. We have also revisited contraception and examined the different methods available and the potential consequences and risks involved.
|
|
|
Year 12 students have wrapped up their Research Methods unit and have been exploring the fundamentals of psychology. Starting with Approaches, students travelled back in time to trace the shift from philosophical thinkers like Descartes and Darwin to ground-breaking psychologists such as Sigmund Freud and Albert Bandura.
They’ve also dived into Cognitive Psychology, studying classic memory models like the Multi-Store Model and the Working Memory Model. In January, students will delve into the practical applications of memory research, investigating the factors influencing eyewitness testimony and how cognitive psychology can enhance police interviews.
Excitingly, Miss Clifford is introducing a Wellbeing Project in the spring term, where students will research and present innovative wellbeing strategies. Watch this space for their recommendations in the Spring term bulletin!
Year 13 students have been working exceptionally hard this term, completing their autumn mock exams, studying biopsychology, and tackling issues and debates in psychology. With Miss Sears, they’ve been exploring the causes and treatments of schizophrenia, while with Miss Clifford, they’ve delved into the fascinating discussion of criminal behaviour – was Ted Bundy born or made into a serial killer?
Both topics have facilitated an excellent discussion into nature vs nurture allowing for some interesting debates!
Celebrating Our Psychologists of the Month!
A huge congratulations to our outstanding psychologists of the month. November’s stars were Jonty (Year 12) and Fred (Year 13), while December celebrated Naomi (Year 12) and Vianca (Year 13). These exceptional students are shining examples of dedication to psychology, excelling in assessments and homework while showing genuine passion for the subject.
As a reward, each student received an R3 and the opportunity to choose a book from the Psychology library.
 Fred picked one of Miss Clifford’s favourites ‘How are Emotions Made – The Secret Life of the Brain’ a recently published exploration of the neuroscience behind emotions by Lisa Fieldman Barret. Fred picked one of Miss Clifford’s favourites ‘How are Emotions Made – The Secret Life of the Brain’ a recently published exploration of the neuroscience behind emotions by Lisa Fieldman Barret.
Jonty picked one of Miss Sears’ favourite ‘The Lucifer Effect’ by Zimbardo.
Both books are excellent Christmas presents for anyone interested in human behaviour!
Next term promises even more excitement! Year 12 will have their wellbeing projects and dive into topics like Clinical Psychology and Year 13 will tackle Cognition and Development and statistical analysis in research.
We hope everyone enjoys a well-earned Christmas break. Here’s to an inspiring new term filled with discovery and innovation!
|
|
|
Year 13:
Year 13 have been busy this half term debating some of the challenges to Christianity including whether science has made religion obsolete and how and whether salvation is an option for atheists and those who have been excluded from religion. It’s great to see our students growing in confidence and eager to share their views. An intervention timetable will be shared at the start of the spring term, please encourage your child to attend these sessions and to continue revisiting previous topics at home.
Year 12:
Our Year 12 students have continued to make good progress. We have been studying the problem of evil and examined theories on where evil comes from and how God fits into a world where evil and suffering exist. After Christmas, we will start to prepare students for their February mock exams. Please encourage your child to start their revision early and to attend the revision sessions on offer.
Year 10:
Our Year 10 students have been exploring issues of Human rights and we have enjoyed lots of interesting discussions on how the declaration of Human rights is interpreted and used the UK and around the world. Some advance notice that Year 10 will be sitting their second RE mock exam on Wednesday 11 February. Revision resources for this will be available on Go4schools from 19 December to allow students plenty of time to prepare for this. If you have any queries about this or how to support your children to revise at home, please contact the RE team.
Year 9:
Year 9 students have been working on Christian beliefs this half term which is part of Paper 2. They have been exploring the key events in the life of Jesus and the impact of these on individuals and society. Please encourage your child to check Go4schools regularly so that they can access all homework tasks and revision materials which will consolidate their learning.
Year 8:
We are currently studying the problem of evil and again Year 8 have produced some fantastic collages depicting natural and moral evil in the world. We have been very impressed by the level of maturity and empathy shown during discussions on the suffering caused during the Holocaust.
Year 7:
 Year 7 have continued to impress us in lessons with their enthusiasm and eagerness to contribute ideas to class discussions. Year 7 have continued to impress us in lessons with their enthusiasm and eagerness to contribute ideas to class discussions.
We have been exploring Buddhism this half term and we have been very impressed by the effort they have put into the completed homework projects so far.
Well done Year 7!
 
|
|
|
Year 7 – Properties of elements and compounds
This term, Year 7 students conducted an exciting hands-on practical, to
investigate and compare the physical properties of sulfur, iron, and iron sulfide, focusing specifically on magnetism and electrical conductivity. This practical helped students understand how elements behave individually and how their properties change when they chemically combine.
 Students worked in small groups to test these three substances. They performed two tests on each substance. These were magnetism, to check whether the substance was attracted to a magnet and electrical conductivity to determine whether the substance could conduct electricity. Students worked in small groups to test these three substances. They performed two tests on each substance. These were magnetism, to check whether the substance was attracted to a magnet and electrical conductivity to determine whether the substance could conduct electricity.
At the end of the practical, students were able to identify the differences between elements (iron and sulfur) and a compound (iron sulfide), recognise that chemical reactions create new substances with new properties, safely handle equipment and record observations in order to compare results scientifically. Students were fascinated to see that although iron is magnetic and conductive, and sulfur is neither, the compound iron sulfide does not behave like iron at all. This helped them understand that chemical reactions change the identity and behaviour of substances.
 Year 8 students have seen an exciting live demonstration exploring the alkali metals and their chemical properties. Year 8 students have seen an exciting live demonstration exploring the alkali metals and their chemical properties.
They watched as small pieces of lithium, sodium and potassium were carefully added to water, observing the increasingly vigorous reactions first-hand.
The demonstration helped students understand key ideas from their chemistry curriculum, including:
- how alkali metals are stored and why they must be handled with care
- the characteristic reactions of Group 1 metals with water
- the production of alkaline solutions and hydrogen gas
- how reactivity increases as you move down the group
Students were enthusiastic and engaged throughout, asking thoughtful questions and making excellent scientific predictions based on the patterns they observed.
Year 9 students have been looking at purity and separation techniques and developing their understanding of the scientifically pure. They have drawn graphs and developed key terms to evidence the difference between substances that are pure and those that are impure. They also carried out practicals to test for substances that might be found in bottled water and how this differs from distilled water.
 
 Year 9 students have also continued their journey through Science’s spiral curriculum and studied magnetic fields. They have deepened their knowledge discovering the shape and direction of magnetic fields around permanent bar magnets and solenoids. At A Level Physics students continue magnetic fields when delving deep into the Physics governing magnetic fields, such as Faraday’s Law and Lenz’s Law. Year 9 students have also continued their journey through Science’s spiral curriculum and studied magnetic fields. They have deepened their knowledge discovering the shape and direction of magnetic fields around permanent bar magnets and solenoids. At A Level Physics students continue magnetic fields when delving deep into the Physics governing magnetic fields, such as Faraday’s Law and Lenz’s Law.
Year 10 students have been studying the topics of genetics, inheritance, variation, and cell division. To strengthen their understanding, we took the opportunity to recap mitosis before moving on to the more complex process of meiosis.
 As part of this recap, students worked collaboratively to model the stages of mitosis, bringing abstract concepts to life in a creative and memorable way. This helped them connect prior learning with new ideas, reinforcing how cell division underpins genetic variation and inheritance. As part of this recap, students worked collaboratively to model the stages of mitosis, bringing abstract concepts to life in a creative and memorable way. This helped them connect prior learning with new ideas, reinforcing how cell division underpins genetic variation and inheritance.
Our Year 11 Triple Science students applied their knowledge of chemistry to a fascinating practical experiment: creating casein glue from milk and vinegar. Using the principles of acid-base reactions and protein denaturation, students successfully separated the milk's main protein, casein, from the liquid whey by adding ethanoic acid (vinegar). They then neutralised the remaining acid with sodium hydrogen carbonate (baking soda), observing the tell-tale bubbles of carbon dioxide gas as part of the neutralisation reaction. This solid casein forms a strong, natural polymer, demonstrating how everyday food chemistry can be harnessed to produce useful adhesives.
It was a great opportunity for the students to see how theoretical concepts translate into a real-world product!
 

 
Year 12 CPAC: Exploring Factors That Affect Enzyme Activity
Year 12 students have completed a Controlled Practical Assessment (CPAC), which focused on enzyme activity—a fundamental topic in their A-level Biology . This investigation provided a fantastic opportunity for students to deepen their understanding of how enzymes function, with a specific focus on the effect of substrate concentration on enzyme activity.
The practical was carefully designed to assess a range of competencies essential for their scientific development:
- Following a Method: Students demonstrated precision and attention to detail as they carried out the experiment according to the established protocol.
- Tabulating Results: They showcased their ability to record their findings systematically in well-organised tables.
- Writing a Conclusion: Using their data, students constructed clear, evidence-based conclusions to answer the investigation’s central question.
- Evaluation: They reflected on the reliability and validity of their results, identifying potential improvements for future experiments.
The practical explored how varying substrate concentrations influence the rate of enzyme activity. This involved using specialised equipment and techniques to measure reaction rates accurately. Students excelled in applying their theoretical knowledge, ensuring accurate observations and reliable data collection.
Their ability to combine scientific observations with advanced practical techniques resulted in some truly fantastic outcomes. Their work demonstrated technical skill and critical thinking as they analysed their results and reflected on the scientific principles underpinning their findings.
The skills honed during this CPAC will be invaluable as students continue their scientific studies, both for the remaining coursework and in preparation for their final A-level examinations.
Year 12 Biology have cultured bacteria in sterile environments using aseptic techniques. This required practical activity brings science to life as students develop the precision and care needed to maintain contamination-free conditions—an essential skill in modern laboratories and medical fields.
Students have been studying the intricacies of the immune system looking at how vaccines work, what are the purpose of B cells and T killer cells and how antibodies help with our response to a pathogen. Students have been studying the intricacies of the immune system looking at how vaccines work, what are the purpose of B cells and T killer cells and how antibodies help with our response to a pathogen.
Students learnt to handle equipment such as inoculating loops, spreaders and Petri dishes while adhering to strict protocols to prevent the introduction of unwanted microbes.
This practical has a focus on problem-solving, creation of risk assessments, fine detailed motor skills and fantastic analytical skills when comparing the effectiveness of different antibiotics. All key attributes for any future career in science or healthcare!
Students have deepened their understanding of how bacteria grow, the differences within species of bacteria, how they thrive and pose challenges in clinical settings.
Year 13 Biology students have been exploring one of the most important processes in nature: photosynthesis. As part of their required practical work, students investigated how different factors influence the rate at which plants convert light energy into chemical energy.

The practical allowed students to apply key A-Level concepts, including enzyme activity, limiting factors, and plant physiology, while developing essential experimental skills such as forming hypotheses, controlling variables, and collecting and analysing data.
Along with reinforcing theoretical learning, this investigation encouraged students to think critically about how environmental conditions affect plant growth—an issue increasingly relevant in the context of climate change and food security. We are proud of the maturity and scientific thinking shown by all students throughout this challenging and engaging piece of work.
Year 13 Chemistry - Synthesis of Aspirin
 Year 13 Chemistry students have been deepening their understanding of organic chemistry this term, including a focus on the synthesis and analysis of important compounds. As part of their studies, they completed a Required Practical where they prepared, purified, and tested the purity of aspirin, one of the most widely used medicines in the world! Year 13 Chemistry students have been deepening their understanding of organic chemistry this term, including a focus on the synthesis and analysis of important compounds. As part of their studies, they completed a Required Practical where they prepared, purified, and tested the purity of aspirin, one of the most widely used medicines in the world!
 
Students synthesised aspirin by reacting salicylic acid with ethanoic anhydride in the presence of a catalyst. They then purified their product through recrystallisation, including using a Buchner funnel, which was new to students - a key technique used in pharmaceutical chemistry to ensure a pure and effective medication.
 
To assess the purity of their aspirin, students conducted melting point analysis, comparing their results to known values to determine the success of their synthesis.
This practical reinforced key organic chemistry concepts and helped students develop essential laboratory skills, including precision, analytical thinking, and problem-solving. Such experiences are invaluable for those considering future studies and careers in chemistry, medicine, or related scientific fields.
Year 13 Physics – Electromagnetic Induction in Action
During this term, Year 13 have deepened their understanding of magnetic fields and electromagnetic induction. Through a series of practical investigations, they have explored how moving magnets, coils, and changing magnetic fields can generate electrical energy. They also looked at how supplying electrical energy to a coil can produce rotation in a motor.
A highlight of this was when students built their own Westminster motors. They assembled these simple electric motors and carried out investigations to see how changing different inputs, such as the strength of the magnet or number of turns in the coil, affected the motor’s speed and motion to help them to apply theory learnt with real engineering systems.
 
|
|
|
Our Year 12 Sociology students have now reached the last of the five topics for Education, having explored the range of differences in achievement across social class, ethnicity and gender and the role of education. Is it to develop obedient workers of the future, in a capitalist economy, or is it to develop specialist skills to participate in the labour market, for the many diverse careers and opportunities that exist? And what place might AI have – will it replace teachers!? Students have explored the theoretical arguments for these and have applied to their own context. They may have shared some of these views with you at home and we hope they do – these topics lend themselves to good debate at home!
The students have recently completed interleaving assessments in Paper 1 (Education) and Paper 2 (Families and Households) building their skills development and practise in assessments ahead of mocks. Students prepared well and are refining their revision skills and development of their resources.
As we are examining patterns and trends in society, just a reminder for students to be abreast and aware of contemporary news and developments which we often highlight in our lessons. Students can read/watch/listen to some news platforms weekly, which will give them ever more contemporary examples they can use to complement their studies and refer to in exam questions.
 Suggested Christmas reading and watching can be located in our Curriculum reviews and perhaps may even provide some suggestions for Christmas presents! Suggested Christmas reading and watching can be located in our Curriculum reviews and perhaps may even provide some suggestions for Christmas presents!
A personal favourite of ours is ‘Invisible Women’ by Caroline Criado Perez- the Sunday Times number one bestseller exposing the gender bias women face every day.
Year 13 students are now onto their final topics of Year 13 content, Paper 2: Beliefs in Society & Paper 3: Crime & Deviance. In paper 2 students have begun to cover a range of knowledge looking at the patterns and trends in religiosity, how religion has created social stability and change and the types of religious organisations that exist from more traditional or new religious movements and the growing popularity of New Age movements.
In their Crime and Deviance unit students again have been exploring the patterns and trends in criminal behaviour across different social characteristics and how crime and deviance trends have changed as a result of globalisation. Students have been exploring the world of corporate crime looking into the criminal cases such as the Volkswagen emissions scandal and looking into crimes of the wealthy including the criminal convictions against Donald Trump.
We were fortunate to spend some time in Warwickshire Crown Court in Leamington to support their studies and see the realities of the Criminal Justice System.

Senior Student leader of Sociology, Jaydon says of the visit…’
As we have started the crime and deviance topic, we went on a school trip to the Warwickshire Justice Centre right here in Leamington Spa. We were able to access both Magistrate and Crown Courts during our trip, where we observed a large range of cases, from petty crime such as theft to more serious cases, such as manslaughter. It helped us to develop a better understanding of how the legal system works in our country and we found it a very interesting trip. For example, we thought the trip gave a raw representation of crime, especially since TV doesn’t give the full picture and makes it feel very distant from everyday life. It felt a very authentic experience and many of us said we would like to go to the courts again in our own time!
|
|
|
On 5 December, all our A-Level Art, Photography and Textiles students had the opportunity to visit three major art galleries in London: the Victoria and Albert Museum, Photographers’ Gallery and the National Portrait Gallery. This trip enabled students to see and appreciate high-end art and support them in completing their coursework to a higher level of critical understanding which is particularly important for Assessment Object 1 that looks to see connections made between artist’s and student’s work.
At the National Portrait Gallery, students saw the permanent collection and a very exciting opportunity to see the Cecil Beaton exhibition. Photography students had an opportunity to see the Taylor Wessing Photo Portrait Prize before the Photographers Gallery at the National Portrait Gallery with a range of contemporary exhibitions for all the students to view.
At the Victoria and Albert Museum, the students saw a wealth of different styles and cultural art, photography and textiles and textiles students additionally visited the Marie Antoinette exhibition.
Students were set specific tasks based on their subject area for all three galleries, to ensure the very most of our time in London was made with the aim of them being able to show a sophisticated level of primary research in their coursework projects (worth 60% of their overall grade). They were able to take photographs and record their finding throughout the day.

|
|
|
It’s been another fantastic half term with all students consolidating their learning into much stronger outcomes.
Year 7
Students have applied their knowledge of the FORMAL ELEMENTS, in a series of still life recordings and outcomes with great success.
They have also completed the colour wheel and learning tasks on tints, tone and shades. This has led onto some impressive paintings. 
Year 8
Students choose five natural forms to record from, recording the shape, texture and form of these in materials they enjoy. Here are some great examples from their sketchbooks.

Students then planned and completed a larger final piece using their learning, adapting the scale of their sketchbook recordings and considered colour, materials and background for effect.
They have been testing out a mock up final piece to complete an A3 version.
 
 Year 9 Year 9
Students have been developing their mixed media skills, manipulating cardboard, paper and other materials to create relief buildings. They have used their previous drawings of buildings effectively to create these impressive outcomes.
 
 Year 10 Year 10
Students have chosen one, of six, starting points for their sustained investigation for their non-examined assessment (NEA) component 1.
Students have been investigating Artists to respond to and have photoshoots, drawings and ideas created in their sketchbook.
 
After Christmas they will take their best idea into several responses and create a final piece.
Our Year 11 students have completed their NEA’s for coursework which concluded with the mock exam on December 12. Congratulations year 11 , the NEA 1 component is worth 60% of their grade.
Their sketchbooks are full of fascinating and individual research and responses. Students have used class time for their final outcomes, producing fantastic pieces, in a variety of materials and scales. Whilst we cannot show work at this final stage, we are proud of our student’s engagement in their final pieces.
On return Year 11 will receive the external set task and will choose a new starting point for NEA 2. The Department will have intervention sessions running after school on a Tuesday and Thursday to support students with the preparatory work to be completed prior to their two-day exam in April.
 Year 12 have started their short personal investigation preparing them for their A level which will start after Christmas. There is such a wealth and variety of art they are studying. Below are examples of their artwork so far. They are doing an amazing job, as they continue to explore materials and find their own personal style. Year 12 have started their short personal investigation preparing them for their A level which will start after Christmas. There is such a wealth and variety of art they are studying. Below are examples of their artwork so far. They are doing an amazing job, as they continue to explore materials and find their own personal style.
 
Year 13 Students are on the final stages of their NEA component 1 personal instigation worth 60% of their final grade. They have been working hard on refining and tweaking this final pieces to realise their intentions. Students have worked hard and have pages and pages of work completed for component 1.
In February the exam board will send a list of starting points and student must complete an exam project based on this. This is an exciting time for students, and I wish them all the best over the coming months.
|
|
|
It has been another busy and creative half-term in the Photography Studios. Our Year 11 and Year 13 students have been working hard to complete their Component 1 coursework, while other year groups have been exploring a range of media and techniques to produce some impressive work.
Some Year 7 students had the opportunity to build on the ‘still life’ skills they developed in Art by creating their own photographic interpretations of still life. Here are some of their creations.

  
Year 9 students are coming to the end of their first term of Photography lessons and have been investigating how different lighting can alter tone and atmosphere. They have been inspired by the photographer Francis Bruguière and are currently creating images in response to this.
Year 10 students have shown real motivation this term. Having completed their second mini-project on Portraiture, they have now selected their main Component 1 theme. They began by carrying out thorough research into their chosen titles, exploring relevant photographers and other contextual sources. They are currently creating responses to these initial inspirations and experimenting with a variety of media. Below are some examples from their Portrait mini-project.
  

Year 11 and Year 13 students are completing their first Outcome for Component 1, with the deadline for Year 11 the end of this term and for Year 13 the end of January. After this, it will be full steam ahead as they use their time to prepare for their Component 2 exam. These will take place on 27–28 April for GCSE and 5–7 May for A Level.
Year 12 students have completed their initial set of mini-projects, which introduced them to varied lighting setups, darkroom techniques, projection workshops and camera skills. They have moved on to their next project, Tell Me a Story. In this unit, they have considered how narrative functions in visual storytelling and exploring the power of the photographic image. Here are some of their visual explorations.


 

|
|
|
Students have been busy this half term completing many practical project final pieces. With years 11 and 13 working hard on completing component 1 coursework projects, that accounts for 60% of their final grade. They will then move onto the final exam project in the New Year. We look forward to sharing images of their work after the exams have been completed.
Year 7 – students have been using their embroidery skills to design and make a 3D soft sculpture, a doughnut inspired by pop art .
 
Year 8 – have been bringing the various cultural patterns and textiles techniques together to complete a place mat and coaster using batik, weave, press print and dot painting.
 
Year 9 – have chosen to design and make either a scarf, tote bag or tshirt inspired by previous artist research and experimentation and use of stencil printing. They have been both meticulous and focussed on their work.
 
Year 10 have been looking at the work of mixed media artist Cas Holmes, creating artist inspired samples that help push creative ideas and combine recently acquired skills.

Year 12 have been working on a mini-project to further prepare for the big coursework project next term.

|
|
|
Year 11 Food Preparation and Nutrition Practical Assessment
Our second NEA has been very much a priority for our GCSE Food students. Students could select from three tasks –
- Buffet style celebration food
- Producing dishes for a teenager including fruit and vegetables
- Making dishes for an active person
Lots of detail about their practical assessments can be found on Go 4 Schools along with additional resources to help support them in the completion of their assessment. Mrs Ross will be able to offer additional support sessions after school on a Wednesday to ensure all students can really feel confident with this assessment.
The completion of this will contribute towards 35% of their overall GCSE and the deadline will be for the Easter holiday.
 
 
 
Year 7, 8 & 9 Design Technology
It has been fantastic to welcome year 9 back into food, the students have been amazing!! I do hope they are enjoying the year 9 recipes and I look forward to seeing some of them in year 10 for GCSE.
Classes are moving on to their second rotation with Art Textiles, Food Prep and Product Design, the first of these rotations will take place after Christmas. Students will hopefully able to show you some of the lovely items they have made in the workshop or in the food room. Thank you again to parents for supporting us by providing ingredients for the food lessons. If any of you have spare containers such as empty sweet containers or ice cream tubs we would greatly appreciate having these to support students who may at times forget to bring the correct container for their food.
Students have been making some great products throughout their time in food and across KS3 we have focused on the theoretical aspects of nutrition.
Year 7 have been extending their skills making more complex dishes such as spring rolls, muffins and marble cake.

Year 8 have been making pizza, cinnamon rolls, risotto and a new addition for this year was filo pastry parcels.

Year 9 have been making sausage rolls, chow mein, jambalaya and mini calzone.
Year 10 Food
In the New Year students will be continuing to work on the theoretical elements of the course in particular concentrating on the Food Science sections of the course and discovering the impact of sustainability in the food industry.
 A few more complex dishes will be made such as a vanilla slice using a puff pastry and crème patisserie, a roasted vegetable tart, homemade pasta, sacher torte, butter chicken curry and many more dishes. A few more complex dishes will be made such as a vanilla slice using a puff pastry and crème patisserie, a roasted vegetable tart, homemade pasta, sacher torte, butter chicken curry and many more dishes.
These are some photos of our recent practical of soup and bread, although not one of our more complex dishes students have been learning about the process of kneading and gluten formation as well as understanding how to make a thrifty healthy dish from seasonal vegetables.
 
 
 
KS3 Enrichment Activity Opportunity
We are looking to offer Y8 and Y9 new opportunities after school in the next term with a four-week course offering students an opportunity to cook. Students will need to sign up – more details to follow through core comms messages in Tutor Time; it will involve a small group being able to come and cook some more complex dishes. Students will need to be prepared to bring ingredients for the session and a container and those not selected from the first round will be rolled over to the next term.
Year 10 DT
Students have been working with new materials and have been making a product from metal.
 The focus has been on hand tools and using a range of tools to create specific joints. Many of the tasks and projects being taught are skills essential to life beyond the classroom and the current projects are certainly supporting this skill building aspect of the course. Projects planned for the year include Bird Boxes and Storage boxes. The focus has been on hand tools and using a range of tools to create specific joints. Many of the tasks and projects being taught are skills essential to life beyond the classroom and the current projects are certainly supporting this skill building aspect of the course. Projects planned for the year include Bird Boxes and Storage boxes.
Year 11 DT classes have been working on their Non-Examined Assessment (NEA) and planning their modelling; they have completed some excellent design work. The NEA is due to be completed by the end of March and support classes will be offered so please encourage your child to attend these sessions so they can make the most of the NEA which contributes to 50% of their GCSE.
A Level Product Design
Students have almost completed their NEAs which they have been working on for the past year. Whilst the assessment is similar to the GCSE NEA it is a far bigger and more analytical project aimed at students designing a product based upon an everyday problem.
Students are also using their lessons to develop their knowledge of the world of engineering and manufacturing looking at how materials are made and the economic impact of our consumerism.
|
|
|
Following on from last term, when students looked at the Acceptable Use Policy and the Artificial Intelligence (AI), all students revisited the policy and completed a quiz to reinforce their understanding. During Tutor Time, students explored a range of topics designed to build their knowledge of AI, its uses, and its impact on everyday life.
What Is Artificial Intelligence?
Students discussed
- How to define AI
- Examples of AI already used in daily life
- How AI works in familiar contexts and how effective they think it is
- New facts they learned about AI and its capabilities
Designing AI-Powered Gadgets
Students considered the creative question:
“If you could add AI to any tool or gadget, what would it be and why?”
They explored:
- The purpose of their chosen gadget
- One key benefit an AI feature could bring
- Possible positives and negatives of adding AI
- Responsible and safe use of AI within technology
Is AI a Good Idea?
Students took part in debates and discussions about:
- The advantages of AI and the drawbacks
- Examples of AI they already see in the world and their opinions on its usefulness
- Raising awareness around ethics and accountability in AI use
Thinking About the Future
Other questions explored included
- How might AI evolve to further impact everyday life in the future
These sessions have been really useful in helping our students further their AI understanding whilst learning new facts along with an opportunity to discuss and reflect the benefits and challenges of using AI.
|
|
|
 Students in Year 7 & 8 have completed projects on climate, the seasons and animals in our Outdoor Learning Intervention sessions. Students in Year 7 & 8 have completed projects on climate, the seasons and animals in our Outdoor Learning Intervention sessions.
They worked on building their confidence by writing goals, talking about what makes them happy and ways to deal with challenges they may face.
Many have found strategies to reduce their anxieties and worries. Friendships have also been a focus where students discussed how to build healthy friendships and how to manage friendship challenges.
Careers Information Event
On Wednesday 19 November, the SEND Team and Careers Team hosted a dedicated Careers Information Event for selected SEND students and their parents from Years 10–13.
The event provided an invaluable opportunity for families to explore a range of Post-16 and Post-18 pathways, and support that is available to students.
We were delighted to welcome over 50 NLS students and 10 parents, all keen to learn more about the routes available as they plan for the future.
We are grateful to the wide range of organisations that supported the event offering expert advice and guidance.
The event was highly positive and well-received, giving students and families greater confidence and clarity about their next steps. We look forward to continuing to support our SEND learners as they prepare for life beyond school.


|
|
|
Fair Active schools
We are proud to announce that we have achieved the FairAware Award, recognising our commitment to learning about global issues and making informed, ethical choices.
This award celebrates the hard work of our students and staff in understanding how everyday actions can impact communities around the world

It would not have been possible without the dedication and commitment of our Fair Trade Leaders, whose enthusiasm and example have inspired the whole school to get involved. Through class projects, assemblies, and whole-school initiatives, we have deepened our knowledge of Fairtrade and taken meaningful steps toward creating a fairer, more sustainable future.
We look forward to building on this achievement and continuing our journey as a Fairtrade-aware school.
A particular highlight this term has been watching the Fair Trade Leaders deliver assemblies to both Year 7 and Year 8 and run a bake sale to raise money for Fair Trade. The students led the work brilliantly and demonstrated superb commitment to the school.
In tutor time students have also taken part in an International School project focusing on 'Plastic in our oceans' and investigating and debating the issues around single use plastic and how to recycle them well.
|
|
|
At NLS, we utilise the schemes of learning and opportunities that the King's Trust (KT) offers to enable some of our students to achieve a Level 1 qualification.
Our Year 11 students have been working on their units for nearly two years now (with many being in-line to complete six units) and are on track to achieve the Level 1 certificate at the end of their Year 11.
Our Year 10 students have settled in wonderfully well to the course and have completed one module and are working on their second ready to complete before February half-term.
If any students have any outstanding work that has not been entered into their folder, please ask them to submit it, either to me at the address below or to their teacher for The King’s Trust.
 In Year 10, our students have been completing work on Teamwork. In Year 10, our students have been completing work on Teamwork.
Students have been working on their chosen careers, looking at how they would explore this through advertisements, applications and interview.
If any students have any outstanding work that has not been entered into their folder, please ask them to submit it, either to me at the address below or to their teacher for The King’s Trust.

If you wish to have any more information about The King’s Trust, please contact jbarrett@northleamington.co.uk
|
|
|
Sixth form students recently took part in a cooking enrichment activity that brought energy, creativity, and plenty of delicious aromas. Guided by ABM Catering’s professional chef, students were introduced to a range of practical culinary skills, from safe knife techniques to understanding flavour balance and presentation. The chef gave live demonstrations, showing step-by-step methods for preparing fresh dishes and explaining the importance of organisation and teamwork in a real kitchen environment.

Although the students didn’t cook themselves, the session offered valuable insights that will serve them well as they move toward adulthood, university, or independent living. The chef highlighted simple, affordable ways to eat well without relying on expensive ingredients or pre-prepared meals, emphasising that good nutrition doesn’t have to come at a high cost. Students left with a clearer understanding of how thoughtful meal planning and basic kitchen knowledge can support a healthy lifestyle, help them manage their budgets effectively, and build lifelong habits that will benefit them far beyond their time in sixth form.
Science Club
Year 7 students kicked off Science Club with an exciting practical on flame tests, exploring how different chemicals produce the bright colours seen in fireworks. Students investigated a range of flame colours and learnt how these are linked to different metal salts.
As part of the session, students were also trained in the safe use of Bunsen burners and worked towards earning their Bunsen Burner Licence. They showed excellent focus, teamwork and enthusiasm throughout. A brilliant, colourful start to Science Club!
 
Dance Club
A big thank you and well done to our Dance leaders (Laura and Una) in Year 10 for supporting KS3 dance club this term. You have worked hard to choreograph routines and show fantastic leadership skills through teaching younger students, been excellent role models and the younger students have really enjoyed your choreography!
Also, well done to our newly appointed Year 8 dance leaders Evie, Avnii, Myah, Nancy, Isla and Esther who have also been supporting with leading warm-ups and helping students at dance club.
Well done to our Year 7 & 8 dance club and also our Year 9 dance club this term for your enthusiasm and commitment every week – hard work starts after Christmas with more of our Dance Recital 2026 preparation! See you in the New Year.
|
|
|
We were delighted to celebrate all the students who completed their Bronze, Silver and Gold Duke of Edinburgh Awards at our awards evenings in November. These events have now become a fundamental part of our school calendar, giving us the chance to recognise the outstanding achievements of our young people over the last year and present their certificates and badges.
 The Duke of Edinburgh’s Award, at any level, is not easy. It takes effort, determination, and the resilience to overcome obstacles—both physical and metaphorical – and, in this way, the award epitomises our CORE values of Commitment, Opportunity, Respect and Excellence. The Duke of Edinburgh’s Award, at any level, is not easy. It takes effort, determination, and the resilience to overcome obstacles—both physical and metaphorical – and, in this way, the award epitomises our CORE values of Commitment, Opportunity, Respect and Excellence.
To have so many students completing their awards this year is truly fantastic and it was wonderful to celebrate with them on these evenings. We also recognised and thanked the NLS staff who supported with training, route-planning, and the many weekends they dedicated to the expeditions.
This year’s highlights include:
- We had over 125 applicants for Bronze—breaking school records yet again and surpassing almost every school in Warwickshire.
- 118 students completed the Bronze expedition.
- Due to the exceptionally high number of participants, NLS became the largest state-education DofE provider in Warwickshire, and one of the leading providers nationally.
- We achieved one of the highest completion rates in the country, with 81% of students finishing their award—described by the DofE themselves as “far above the DofE average for England and an incredible achievement for the school.”
- Students completed 5,538 hours of volunteering in the local community, equating to an astonishing £35,442 of social value contributed in the last 12 months.
- Alongside their expeditions, students took part in physical activities, learnt new skills, and contributed through volunteering—developing the confidence, independence and resilience the Award is known for.
This year we also began realising our vision of using our own former students as DofE Young Leaders. Our first group of Young Leaders joined us on expedition, giving up time from their university lives to support and guide our younger participants.
Looking ahead, we have four new Young Leaders joining in 2026 and a further twelve the following year—an incredible indicator of the strength of the programme and the desire of our students to return and give back.
Bronze Celebrations
For the Bronze Award students have successfully completed four sections
- Volunteering - three months
- Physical - three months
- Skills-development - three months
- Plus a further three months in either the volunteering, physical or skills section
- An expedition - two days and one night
Growth occurs outside our comfort zone, and our Bronze participants were certainly taken outside of theirs. It was remarkable to watch them grow: learning from mistakes, adapting quickly, becoming more self-reliant, communicating better, collaborating, making decisions, accepting responsibility and supporting one another. These are the skills our young people need as they grow beyond home and school—and it is for this reason that their awards are so deserved.
 
We are delighted that so many Bronze participants have already signed up for Silver.
Silver and Gold Celebrations.
On Thursday 27 November, it was the turn of our Silver and Gold students to be celebrated.
 
 For the Silver award students have again completed four sections over a longer timespan: Volunteering, Physical, and Skills, followed by an Expedition. They committed at least six months to Volunteering and either six months for one section (Physical or Skills) and three months for the other. The expedition was a minimum of three days and two nights. For the Silver award students have again completed four sections over a longer timespan: Volunteering, Physical, and Skills, followed by an Expedition. They committed at least six months to Volunteering and either six months for one section (Physical or Skills) and three months for the other. The expedition was a minimum of three days and two nights.
At the awards evening, we remembered the cold training day that began the Silver cohort’s journey, followed by the practice expedition in the Peak District. As with all our expeditions this year, the weather was kind, and students completed long days of walking—around seven hours each day. They were an absolute credit to their parents, to the school and to themselves.
One of the most wonderful aspects of DofE is the absence of phones or devices. Students simply enjoyed each other’s company—talking, laughing, playing games, and being young people. This Silver group embraced this fully.
During the qualifying expedition in July, the weather was unusually hot. Students coped brilliantly, managing the conditions with extra water stops and electrolytes. They should be incredibly proud.
Gold Award Success
 Finally, our Gold cohort. Finally, our Gold cohort.
They have completed five sections: Volunteering (12 months), Physical (12 months), Skills (six months), Expedition (four days/three nights) and a residential.
They are a special group—not only because many have completed Bronze, Silver and Gold all through North Leamington School, but also because they are among the strongest navigators we have ever trained. We can confidently say each of our Gold participants could hold their own against anyone completing the Hill and Moorland Leader Award training some of our staff have completed.
Their Gold expedition journey began on a crisp Thursday in March in the Dark Peak, followed by a practice expedition in the Brecon Beacons in June, and finally their qualifying expedition in Snowdonia. Video footage shown at the Awards evening captured beautifully the landscape and the challenges they faced and overcame.
 
Our Gold students will receive their awards at Buckingham Palace in May—a fitting culmination to years of commitment and effort.
We really appreciated everyone who could join us for our Duke of Edinburgh Award evenings. Thank you to the parents and carers for supporting their child and enabling them to take part in DofE and to our students for being the exceptional people you are and for making this programme such a joy to run.
Looking Ahead
We look forward to our new Bronze participants starting their journey this year, supporting those progressing to Silver, and celebrating our new Gold cohort beginning the last leg of their journey.
If your child has signed up to be a part of the Bronze and Silver DofE Award in 2025-26, they should by now have logged in to their online portal at Sign In | eDofE. Their log in details will have been sent to their school email but if anyone is missing theirs, please email jbarrett@northleamington.co.uk
After logging the activities for the Volunteering, Physical and Skills sections students should now be undertaking these so they are completed in time for next year’s awards’ celebrations.
Students must have an assessor’s report completed for each section. Evidence in the form of photos and records are all appreciated but it is the assessor’s report that is the defining factor when signing off a section. They do this at https://edofe.org/ and either ask their assessor to complete the report in their DofE books and then upload a picture to their eDofE profile in the relevant section or use the link https://www.dofe.org/assessor/ so that assessors can input the report directly onto the site. If you did not receive a welcome pack and would like to use the Assessor’s Reports in that, you can download your own copy at from our Digital Learning Hub.
 If you wish to have any more information about The Duke of Edinburgh’s Award, please contact jbarrett@northleamignton.co.uk If you wish to have any more information about The Duke of Edinburgh’s Award, please contact jbarrett@northleamignton.co.uk
|
|
|
|
|
|
|